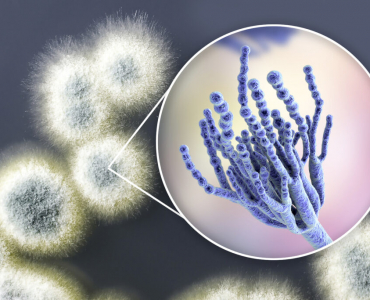

Każdy kto czyta ten artykuł musiał kiedyś chodzić do szkoły, gdzie nauczył się tej skądinąd pożytecznej umiejętności, jaką jest czytanie.
Czytaj więcej
Półpasiec to choroba, która prześladuje głównie ludzi po pięćdziesiątym roku życia. Wywołuje ją ten sam wirus, który wywołuje ospę wietrzną.
Czytaj więcej
Jak już kiedyś pisałem bakterie jelitowe mogą w ten czy inny sposób wpływać na nasze zdrowie, a także na nasze
Czytaj więcej
Wprawdzie nie będzie specjalnie wielkim odkryciem stwierdzenie, że nadeszła wiosna, ale przygotowanie do niej wymaga już pewnego wysiłku. Może nie
Czytaj więcej
W ubiegłym tygodniu rozpocząłem pisanie na temat wpływu insuliny na wagę ciała, a właściwie na na jej niekontrolowany przyrost. W
Czytaj więcej
Jednym z najczęściej opisywanych hormonów wytwarzanych w ciele ludzkim jest insulina. Wytwarzają je tak zwane komórki beta znajdujące się w
Czytaj więcejCzarna pleśń (black mold, mildew) jest najbardziej rozpowszechnionym rodzajem pleśni z jakim przychodzi się nam spotykać. Jednocześnie jest ona prawdopodobnie
Czytaj więcej
Wystarczy spojrzeć za okno, aby zorientować się, że pogodę to mamy raczej w kratkę. W jednym dniu mróz, zawieje i
Czytaj więcej